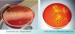
XLD-агар

XLD-агар
XLD-агар сухой
Питательная среда для выделения и дифференциации патогенных энтеробактерий, в частности, сальмонелл и шигелл при проведении бактериологических исследований в клинической и санитарной микробиологии.
Данный продукт имеет Регистрационное Удостоверение.
Фасовка 250 г для приготовления 4,6 л среды.
Срок годности 2 года.
- Стерильность: -
- Форма выпуска: Порошок
- Упаковка: 250 г
- Документы: Регистрационное Удостоверение